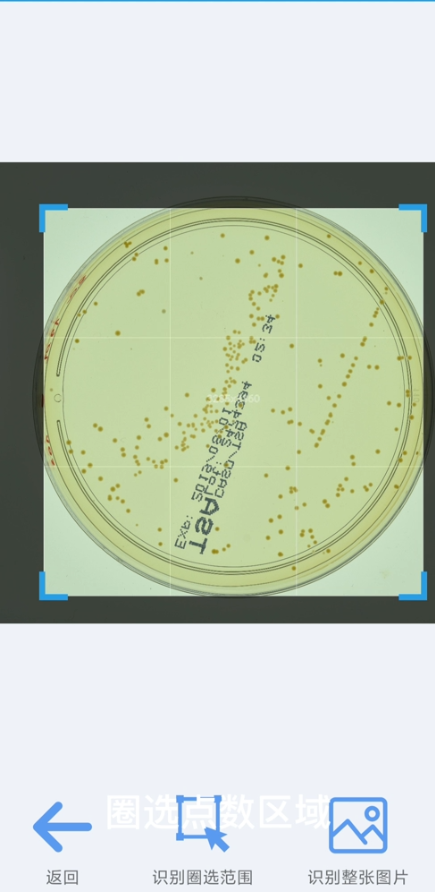

细菌培养在医疗,畜牧,农林业都是非常重要的研究方法.细菌培养免不了需要点数细菌数量.但是常用的点数方式非常费时费力,且存在误差,而且不好记录.
随着科技的发展,人工智能越来越先进.只需要一部手机,几十秒完成之前需要几十分钟完成的工作.大大提高效率.误差小,速度快,记录清晰.
打开软件,选择需要点数的图片,或直接拍照.软件对环境没有什么要求,只要拍的清晰即可.

手机软件计数器app自动识别图片中细菌菌落数量
第二步,选择需要识别的区域,拍照难免会有多余区域,圈选可以提高识别的速度.
手机软件计数器app自动识别图片中细菌菌落数量

手机软件计数器app自动识别图片中细菌菌落数量
如果您对我的文章感兴趣,欢迎留言或私信交流.